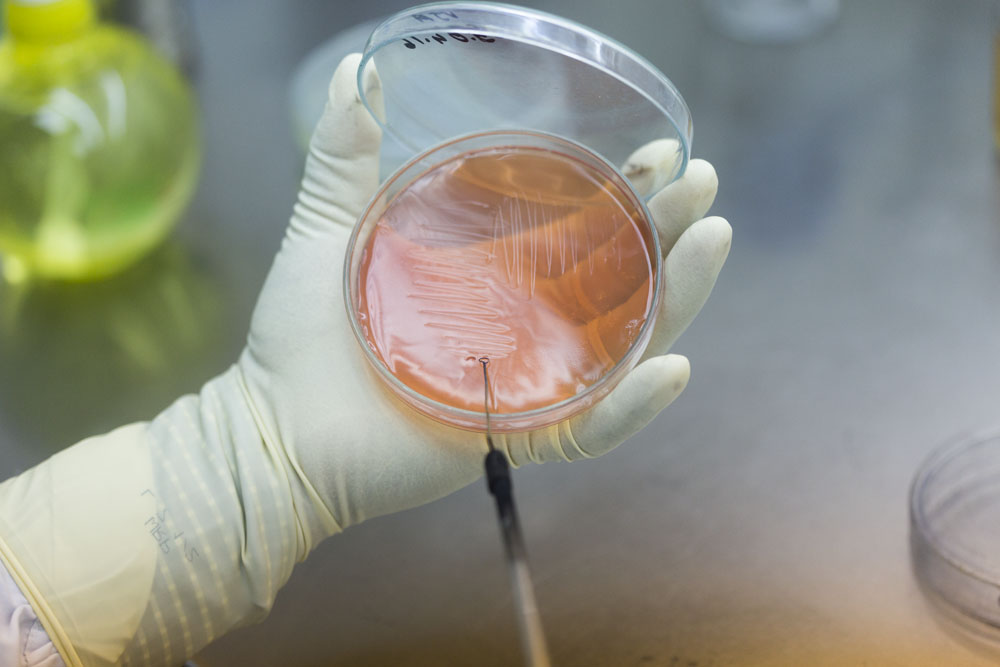

710公海赌赌船有限公司自成立以来,秉承“质量是企业生存之本”的管理方针,将产品做精、做细、做专,通过一流的设备、先进的工艺、严格的生产质量管理,确保生产高标准、产品高品质,产品在市场上获得了良好的社会赞誉,所生产的药品已被联合国儿童基金会、无国界医生组织等众多国际人道主义组织列入采购目录。
购买碧康制药产品,不必担心它的药品质量、安全性和药物有效性。碧康制药在政府职能部门的有效监管下,严格按照欧盟药典和美国药典等国际标准,建立并实施严格的产品质量管理体系,确保药品质量完全符合欧盟和美国药曲现行标准,并正在不断优化管理系统内的质量管控、生产管理、包装标签、物流配送、设备设施、科技研发和业务流程等诸多细节。
碧康制药,粒粒见效!作为事关民生大业的医药行业,碧康制药,将一直视质量为企业生存与发展之本!
购买碧康制药产品,不必担心它的药品质量、安全性和药物有效性。碧康制药在政府职能部门的有效监管下,严格按照欧盟药典和美国药典等国际标准,建立并实施严格的产品质量管理体系,确保药品质量完全符合欧盟和美国药曲现行标准,并正在不断优化管理系统内的质量管控、生产管理、包装标签、物流配送、设备设施、科技研发和业务流程等诸多细节。
碧康制药,粒粒见效!作为事关民生大业的医药行业,碧康制药,将一直视质量为企业生存与发展之本!